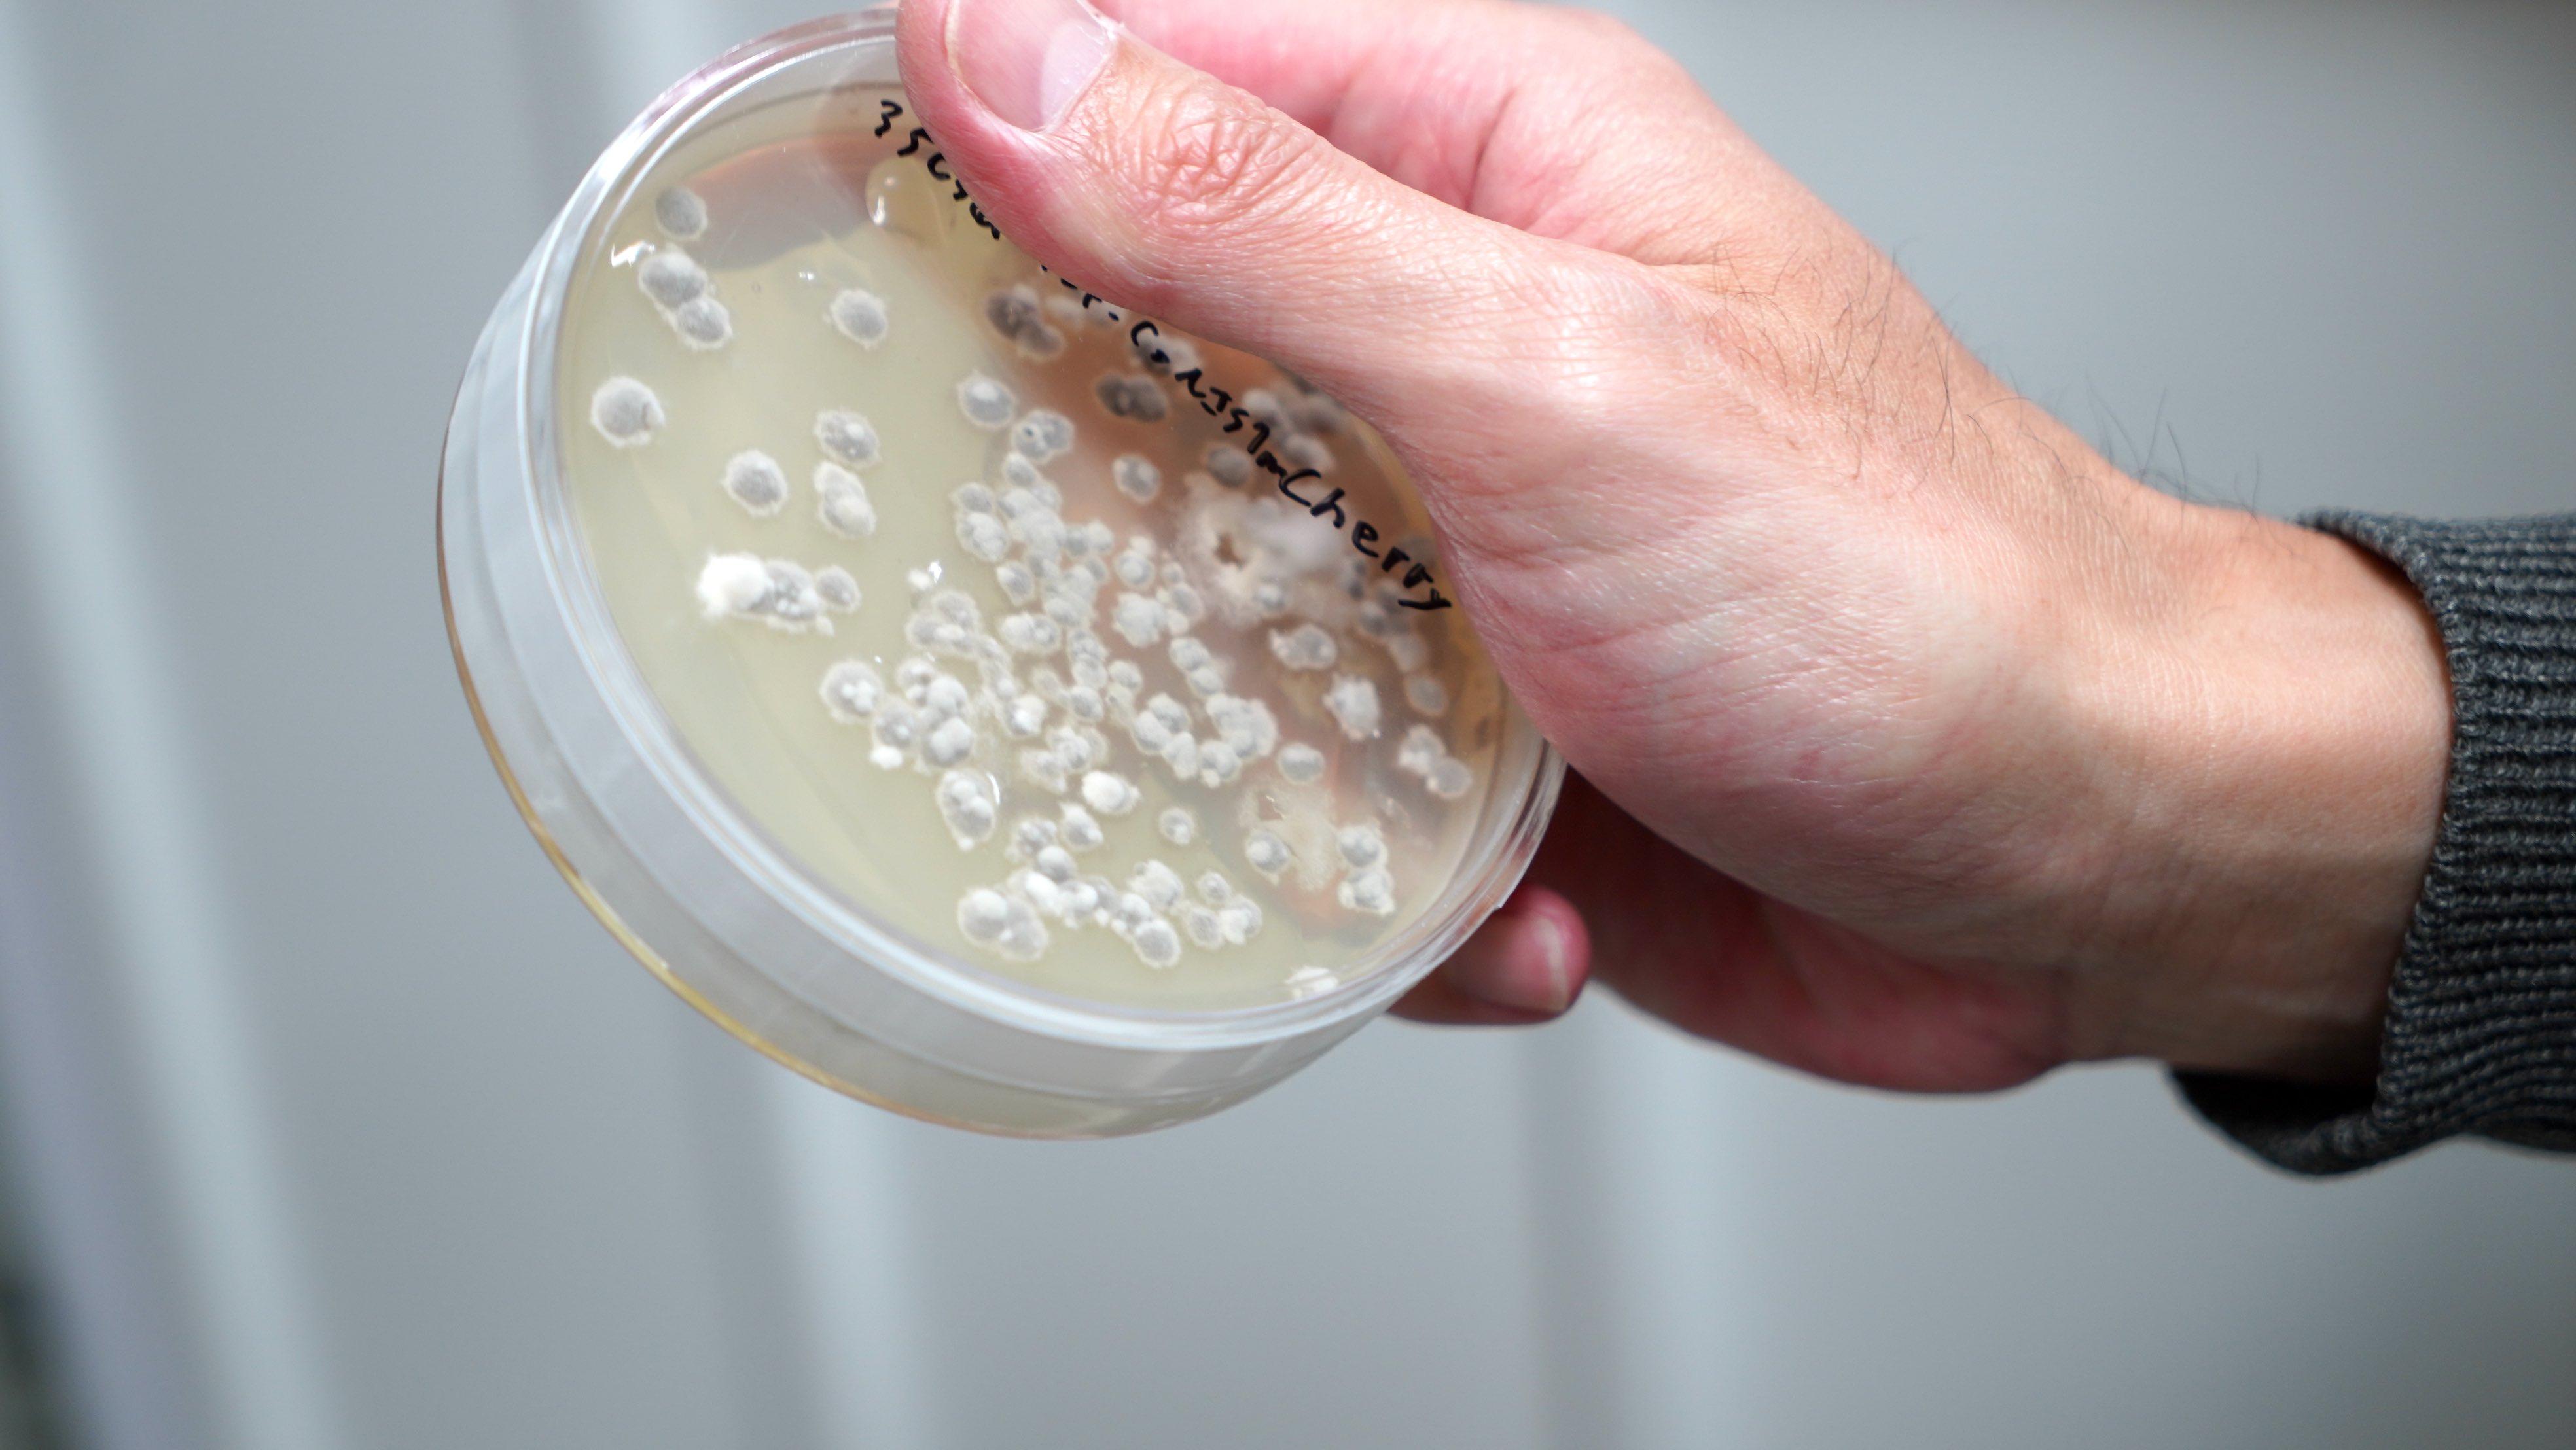

Hiroki Irieda

Please tell me about your specialty.
My specialty is plant pathology. It is the study of plant diseases. Pathogenic microorganisms that infect plants include bacteria, viruses, and filamentous fungi (organisms commonly referred to as molds). Interestingly, 70-80% of plant diseases are currently caused by filamentous fungi. The protection of plants from fungi is an important issue for human beings, who are faced with population, food, and environmental problems on a global scale. It is against this backdrop that we are investigating the fight between fungi, which cause plant diseases, and plants, which have a counterattack mechanism called immunity, at the molecular level. A deeper understanding of elaborate survival strategies of pathogenic fungi and plants that have coevolved over the long history will lead to the development of technology for disease control.

What inspired you to become a researcher?
I have three main reasons.
First, I remember I loved living things (especially butterflies) since I was a child, and I remember thinking that I wanted to be a biologist in the future. At the time, however, I had no concrete plans for my future, and it was just a vague dream.
The second reason is that I was exposed to the fascination of microbes in the laboratory to which I belonged when I was a student. At that time, I was studying the molecular mechanism of bacterial chemotaxis, which is the ability to swim in the water induced by their favorite nutrient source. I was amazed at the clever survival mechanisms of these tiny creatures that could only be observed under a microscope.
Thirdly, as a postdoctoral researcher, I was able to get involved in the field of plant pathology, and I was fascinated by the molecular interactions between the pathogenic fungi and plants. This experience was a major turning point to become involved in my current research.

What are some enjoyable or rewarding moments in your research?
When I make a hypothesis, conduct an experiment, and get the results I expected, it feels good to clear my mind of all uncertainties. I also enjoy it when ideas arise for a new experiment or research topic (whether it works or not). Sometimes I think about research before I fall asleep in my futon and an idea comes to me. Through daily experiments, I find it very rewarding to unravel some of the survival strategies of microbes and plants in terms of pursuing the truth in the natural world.

What's a goal you are striving for now?
Our major goal is to elucidate the interaction between pathogenic fungi and plants at the molecular level and to gain a comprehensive understanding of their infection and defense strategies, which will lead to the development of disease control methods. In particular, we focus on causal agents of anthracnose diseases, Colletotrichum fungi, that include many species and cause infectious damage to a wide variety of plants. However, because research has been conducted on a limited number of Colletotrichum fungi, there are still many Colletotrichum fungi with unknown characteristics. In addition, plants have mobilized many immune pathways to counterattack these diverse fungal pathogens. Our current goals are to discover the interesting infection-related characteristics of Colletotrichum fungi and to identify as many factors as possible that contribute to plant resistance to these fungi.
Could you show us three of your favorite work tools, items, books, and purchases at a conference?
I don't have any particular work tools that I am particularly fond of, but I can think of three that I would dare to mention:

・Preserved flowers given to me by my first students when they graduated that I keep on my desk.


・The Gilson Pipetman set of three (~1,000 µL, ~200 µL, and ~20 µL) is the experiment item I've used the most since I've been involved in research.

・I use a pair of thin tweezers for my own use in plant experiments (they are a bit more expensive).
For more information on Assistant Professor Hiroki Irieda: